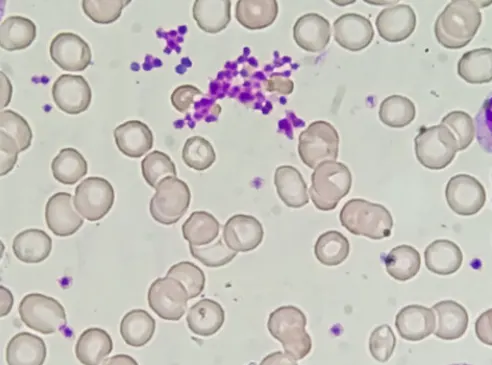
Thrombocyte
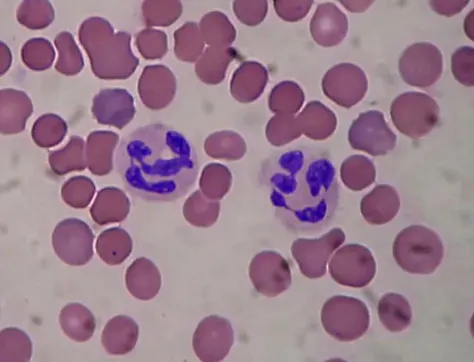
Neutrophil
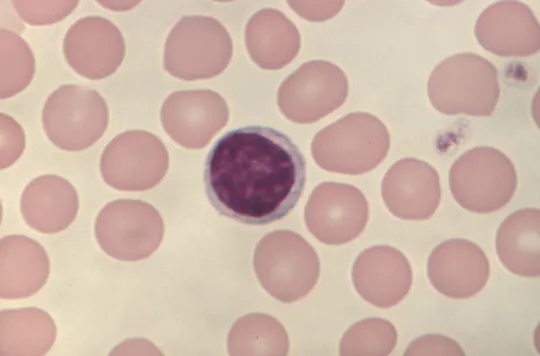
Lymphocyte
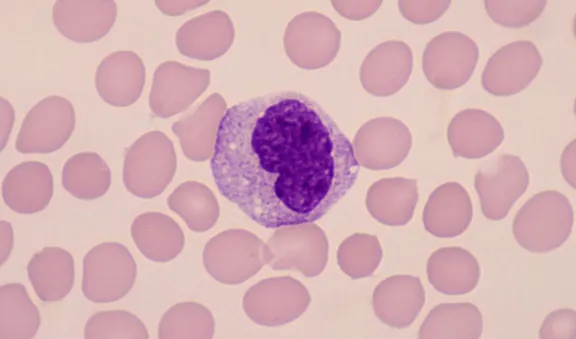
Monocyte
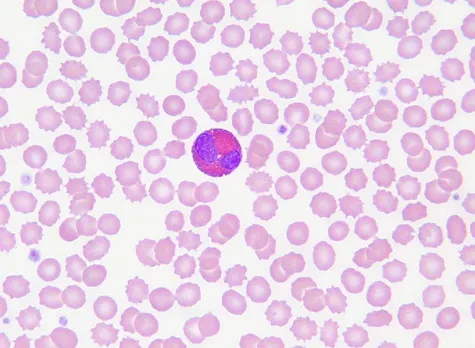
Eosinophil
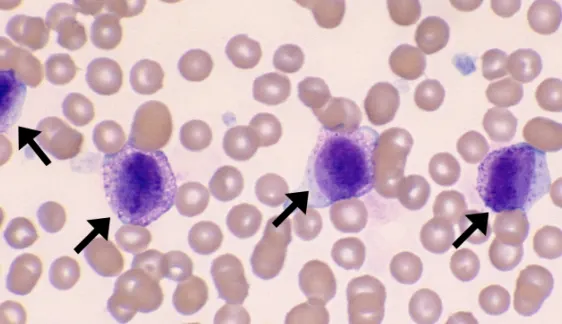
Mast cell

Erythrocyte (Eryth = red; cyte = cell)

- It carries O2 to tissues and CO2 to the lungs.
- It is anucleate and lacks organelles.
- It is biconcave and has a large surface area-to-volume ratio for rapid gas exchange.
- The life span of erythrocytes is 120 days.
- The source of energy is glucose (90% used in glycolysis, 10% used in HMP shunt).
- The membrane contains a Cl−/HCO3 antiporter, which allows RBCs to export HCO3 and transport CO2 from the periphery to the lungs for elimination.
- Anisocytosis is of varying sizes.
- Poikilocytosis is an increase in abnormal red blood cells of any shape.
Thrombocyte (Platelet)
- It is involved in first-degree hemostasis.
- Small cytoplasmic fragments derived from megakaryocytes.
- The life span is of 8–10 days.
- When activated by endothelial injury, aggregates with other platelets and interacts with fibrinogen to form a platelet plug.
- Contains dense granules (ADP, Ca2+) and α granules (vWF, fibrinogen, fibronectin). Approximately 1⁄3 of the platelet pool is stored in the spleen.
Leukocyte (Leuk = white; cyte = cell)
- It is divided into granulocytes (neutrophils, eosinophils, basophils, mast cells) and mononuclear cells (monocytes, lymphocytes).
- WBC differential count from highest to lowest:
Neutrophils (~ 60%)
Lymphocytes (~ 30%)
Monocytes (~ 6%)
Eosinophils (~ 3%)
Basophils (~ 1%)
Neutrophil
- This is an acute inflammatory response cell.
- It is increased in bacterial infections.
- It is phagocytic.
- It has a multilobed nucleus.
- Specific granules contain leukocyte alkaline phosphatase (LAP), collagenase, lysozyme, and lactoferrin.
- Azurophilic granules (lysosomes) contain proteinases, acid phosphatase, myeloperoxidase, and β-glucuronidase.
- Hypersegmented neutrophils (nucleus has 6+lobes) are seen in vitamin B12/ folate deficiency.
- Important neutrophil chemotactic agents: C5a, IL-8, LTB4, kallikrein platelet-activating factor.
Lymphocyte
- Refers to B cells, T cells, and NK cells. B cells and T cells mediate adaptive immunity.
- NK cells are part of the innate immune response.
- Round, densely staining nucleus with a small amount of pale cytoplasm.
B cell
- Part of the humoral immune response.
- It originates from stem cells in the bone marrow and matures in the marrow.
- Migrates to peripheral lymphoid tissue (follicles of lymph nodes, white pulp of spleen,
- unencapsulated lymphoid tissue).
- When antigen is encountered, B cells differentiate into plasma cells (which produce antibodies) and memory cells.
T cell
- Mediates cellular immune response.
- It originates from stem cells in the bone marrow but matures in the thymus.
- T cells differentiate into cytotoxic T cells (express CD8, recognise MHC I), helper T cells (express CD4, recognise MHC II), and regulatory T cells.
- CD28 (costimulatory signal) is necessary for T-cell activation.
- The majority of circulating lymphocytes are T cells (80%).
- CD4+ helper T cells are the primary target of HIV.
Monocyte (Mono = one (nucleus); cyte = cell)
- Differentiates into macrophages in tissues.
- Large, kidney-shaped nucleus.
- Extensive “frosted glass” cytoplasm.
- Found in blood.
Eosinophil (Eosin = pink dye; philic = loving)
- Defends against helminthic infections (major basic protein).
- Bilobate nucleus.
- They are packed with large eosinophilic granules of uniform size.
- Highly phagocytic for antigen-antibody complexes.
- Produces histaminase, a major basic protein (MBP, a helminthotoxin), eosinophil
- peroxidase, eosinophil cationic protein, and eosinophil-derived neurotoxin.
- Causes of eosinophilia
- Neoplasia
- Asthma
- Allergic processes
- Chronic adrenal insufficiency
- Parasites (invasive)
Macrophage (Macro = large; phage = eater)
- Phagocytoses bacteria, cellular debris, and senescent RBCs.
- Long life in tissues.
- Macrophages differentiate from circulating blood monocytes.
- It is activated by γ-interferon.
- It can function as an antigen-presenting cell via MHC II.
- Found in tissue. The name differs for each tissue type (e.g., Kupffer cells in the liver and histiocytes in
- connective tissue).
- It is an important component of granuloma formation (eg, TB, sarcoidosis).
- Lipid A from bacterial LPS binds CD14 on macrophages to initiate septic shock.
Mast cell
- Mediates allergic reactions in local tissues.
- Mast cells contain basophilic granules and originate from the same precursor as basophils
- but are not the same cell type.
- It can bind the Fc portion of IgE to the membrane.
- IgE crosslinks upon antigen binding, leading to degranulation and release of histamine, heparin, tryptase, and eosinophil chemotactic factors.
- It is involved in type I hypersensitivity reactions.
- Cromolyn sodium prevents mast cell degranulation (used for asthma prophylaxis).
Dendritic cell
- Highly phagocytic antigen-presenting cell (APC).
- Functions as a link between innate and adaptive immune systems.
- Expresses MHC class II and Fc receptors on the surface.
- It is called Langerhans cell in the skin.
Plasma cell

- Produces large amounts of antibodies specific to a particular antigen.
- “Clock-face” chromatin distribution, eccentric nucleus, abundant RER, and well-developed Golgi apparatus.
- It is found in the bone marrow and does not typically circulate in peripheral blood.
- Multiple myeloma is a plasma cell cancer.
For more such informative topics on USMLE, follow us on Instagram.
If you want more such notes for your USMLE preparation, join Academically’s USMLE Exam Preparation Course today!
Fill out this form to get one-on-one counselling with our experts.